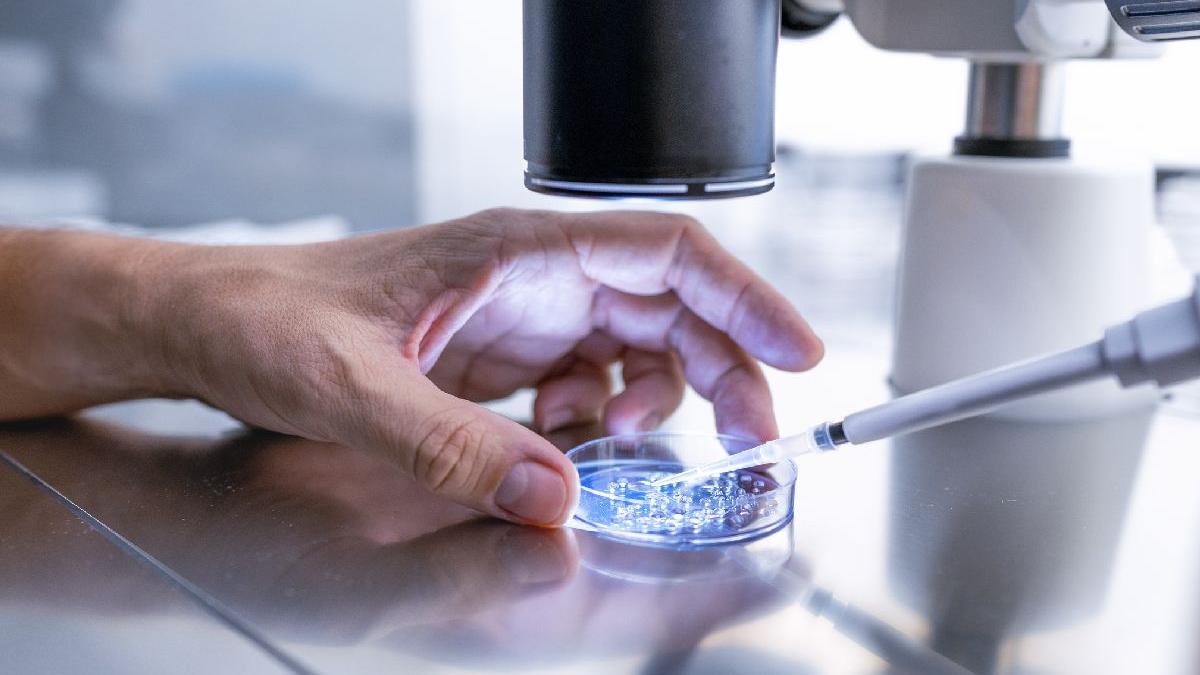
peptide

Robert F. Kennedy Jr, secretarul Sănătăţii din SUA, a transmis că FDA (Administrația pentru Alimente și Medicamente) va adopta, în curând, noi reguli în privința peptidelor, mini-proteinele pe care biohackerii le promovează ca terapii pentru o serie de afecțiuni, iar acestea ar urma să devină mai uşor de cumpărat, notează Politico. "Suntem pe cale să lansăm unul dintre cele mai mari experimente medicale din istoria SUA asupra americanilor, care devin subiecți de testare", a afirmat Alec Ginsberg, specialist în domeniul medical şi director la cea mai veche farmacie din țară.
Peptidele injectabile sunt utilizate pentru orice, de la pierderea în greutate până la recuperarea musculară şi chiar tratamente anti-îmbătrânire.
Robert F. Kennedy Jr ar putea anunţa în curând extinderea accesului la una dintre cele mai mari tendințe în materie de wellness din țară: peptidele, elementele constitutive ale proteinelor despre care biohackerii susțin că ajută la vindecarea rapidă a leziunilor și promovează creșterea masei musculare și pierderea de grăsime.
Kennedy, un autodeclarat „mare fan” al tratamentelor pentru leziuni, pentru care raportează „rezultate bune”, a acuzat Administrația pentru Alimente și Medicamente (FDA) că suprimă agresiv utilizarea peptidelor.
Luna trecută, Secretarul Sănătății din SUA a semnalat o acțiune iminentă din partea FDA pentru a permite ca „aproximativ 14” peptide să fie „mai accesibile” în farmaciile autohtone care produc medicamente.
Kennedy nu a specificat ce va face FDA, referindu-se vag la „un fel de acțiune nouă” după ce agenția va analiza studiile științifice din jurul peptidelor în cauză.
FDA s-a opus peptidelor vândute în farmacii
Există însă și alte semne că sunt probabil în curs de elaborare noi reglementări. Vara trecută, un grup de farmacii care au dat în judecată FDA din cauza poziției sale restrictive privind peptidele au fost de acord să se retragă după ce agenția a declarat că „se așteaptă să prezinte” o regulă finală până în februarie anul viitor, care să abordeze patru peptide pe care companiile doresc să le producă.
FDA ar putea da dovadă de clemență în aplicarea legii împotriva producătorilor de peptide din SUA, cu excepția cazului în care aceștia identifică probleme de siguranță.
"Scopul FDA este de a se asigura că pacienții pot obține produse aprobate de FDA și, atunci când acestea nu sunt disponibile sau nu pot funcționa din cauza situației unice a unui pacient, că acestea sunt fabricate de farmacii americane autorizate, prescrise de un medic și produse conform standardelor de calitate adecvate - nu produse din surse nereglementate sau străine care pot prezenta riscuri pentru siguranță”, a declarat purtătoarea de cuvânt a HHS (Departamentul pentru Sănătate și Servicii Umane al SUA), Emily Hilliard.
Brigham Buhler, proprietarul unei farmacii și clinici de wellness, apropiat de Kennedy, a declarat că înalți oficiali ai HHS „sunt de acord” cu extinderea accesului la peptide.
„Este doar o chestiune de timp”, a adăugat el.
Controversa generată de peptide
Inii farmaciști și medici avertizează că orice mișcare a FDA de a relaxa reglementările actuale privind peptidele ar putea prezenta riscuri grave pentru sănătate din cauza lipsei de date științifice care să le susțină.
Peptidele, care sunt de obicei injectate sub piele, includ insulina pentru terapia diabetului aprobată de FDA și medicamentele GLP-1 pentru slăbit, cum ar fi Ozempic și Wegovy.
Se preconizează că piața globală pentru mini-proteine va ajunge la 100 de miliarde de dolari în următorul deceniu, pe măsură ce companiile farmaceutice urmăresc succesul spectaculos al GLP-1 și cererea tot mai mare de medicină de precizie.
Dar Kennedy promovează substanțele chimice dubios de legale, cunoscute sub denumiri alfanumerice - cum ar fi BPC-157 și CJC-1295 - pentru beneficiile lor pentru sănătate, în ciuda întrebărilor legate de eficacitatea lor și aprobarea de siguranță a FDA.
Aceste produse sunt acum adesea fabricate în China și vândute pe piața neagră. Consumatorii caută, de asemenea, peptide pentru presupusele calități anti-îmbătrânire și de inducere a somnului, pe lângă posibilele beneficii pentru leziuni și compoziția corporală.
Mulți americani preocupați de sănătate, sceptici față de medicina tradițională și precauți față de „Big Pharma”, găsesc aceste tratamente cu peptide prin intermediul influencerilor de pe rețelele sociale, dintre care unii oferă link-uri către produse de calitate îndoielnică. De asemenea, pot fi găsite prin clinicile de peptide care apar în toată țara.
„Suntem pe cale să lansăm unul dintre cele mai mari experimente medicale din istoria Americii asupra americanilor, care devin subiecți de testare”, a declarat Alec Ginsberg, director de operațiuni la C.O. Bigelow, cea mai veche farmacie din țară, referindu-se la lipsa datelor clinice privind utilizarea peptidelor.
Presiune pusă de farmacii
Conform spuselor lui Kennedy, FDA, sub președintele Joe Biden, a reclasificat „ilegal” peste 10 tipuri de peptide, inclusiv BPC-157, în 2023, într-o categorie de substanțe considerate potențial nesigure pe așa-numita listă de ingrediente farmaceutice combinate. Aceasta a făcut ca fabricarea lor să fie ilegală pentru farmaciile specializate.
Ani de zile, farmaciile care produceau medicamente au îndemnat FDA să își relaxeze poziția față de peptide - cu mult înainte ca mișcarea MAHA să le ridice vizibilitatea.
În procesul intentat în 2024 împotriva agenției, grupul de farmacii care produceau medicamente a susținut că FDA, sub Biden, a folosit ilegal reclasificarea peptidelor pentru a amâna adoptarea unor reguli finale privind substanțele care pot și nu pot fi preparate legal.
Producătorii de medicamente compuse spun că FDA a fost prea dură în abordarea sa față de peptide, dintre care unele sunt aprobate în alte țări. Aceștia susțin că preocupările sale legate de siguranță sunt prost definite și că autoritățile de reglementare sunt prea concentrate pe eficacitatea produselor care sunt destinate utilizării doar de la caz la caz.
Americanii, atraşi de peptide
Între timp, atrași de succesul injecțiilor pentru slăbit, americanii sunt din ce în ce mai curioși despre ce pot face alte peptide pentru ei. Dacă FDA va înlesni accesul, „această nebunie pentru peptide va fi la fel de mare ca GLP-1-urile și am văzut cât de repede GLP-1-urile au devenit un termen uzual”, a prezis Ginsberg.
Jessica Duncan, medic specialist în obezitate la platforma de telesănătate Ivim Health, a declarat că tot mai mulți pacienți se interesează de peptide dincolo de GLP-1. Dacă FDA permite prepararea unora, a spus ea, va evalua potențialul lor de utilizare individual.
„Decizia de a lua orice - orice medicament - nu este ceva ce poți lua direct pentru fiecare populație”, a spus Duncan.
Duncan și unii farmaciști avertizează că orice acțiune a FDA nu va însemna că peptidele sunt disponibile imediat. Ar putea dura luni de zile pentru ca lanțul de aprovizionare să treacă de la substanțe chimice destinate cercetării la substanțe chimice de uz uman.
Dacă clienţii le găsesc imediat, a spus Duncan, „puteți fi siguri că probabil nu provin dintr-o sursă de la care doriți să le obțineți”.
Ginsberg a spus că va urmări modul în care acești furnizori descriu produsele pe bază de peptide online. Se întreabă dacă vor face afirmații ferme despre efectele lor sau dacă vor rămâne la un limbaj vag despre potențialele beneficii, similar modului în care sunt comercializate suplimentele.
Perspectiva ca o companie precum Hims să intre pe piața peptidelor și să demonstreze puritatea produselor sale este „cu siguranță o îmbunătățire față de situația actuală pe care o avem” cu piața gri, a spus Ginsberg.
„Asta nu înseamnă că este bine pentru tine”, a adăugat el. „Înseamnă doar că este mai bine pentru tine decât ceea ce făceai înainte.”